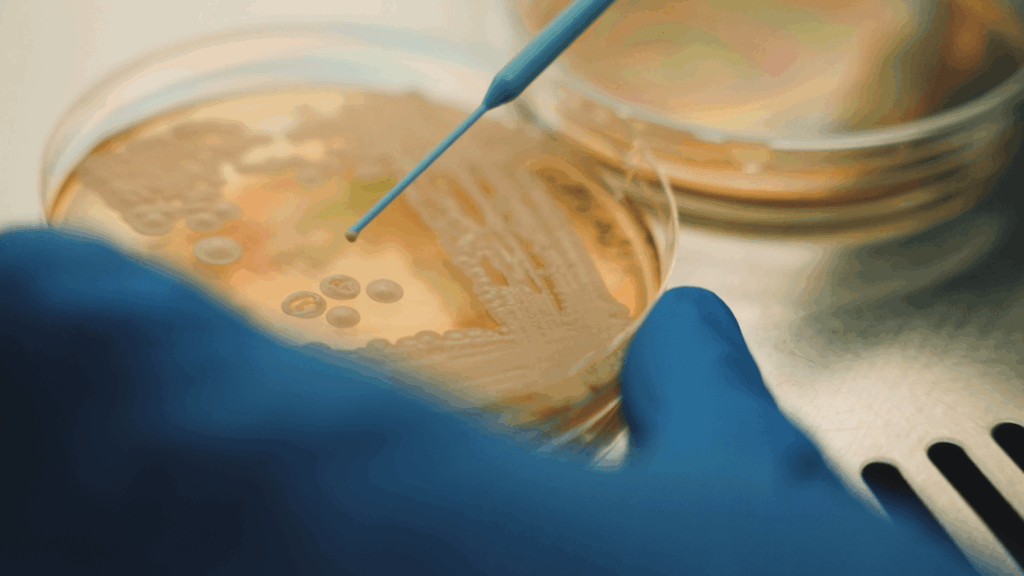

Better Dairy pioneers precision fermentation of human milk bioactives like osteopontin, unlocking nature’s elite nutrition for the booming nutraceuticals market. CEO Jevan Nagarajah targets US approval in June 2026, with B2B partnerships gaining momentum.
Human milk packs nature’s premier bioactive proteins for bone strength, immunity, gut health, and cognitive development – vital from infancy but absent later, as cow’s milk can’t replicate them. This gap starves supplements for menopause, osteoporosis, aging, sports recovery, and child wellness, blocking breakthroughs in a sprawling, innovation-hungry sector.

Better Dairy’s biotech harnesses precision fermentation to produce osteopontin – a milligram-powerhouse for bone health, immunity, gut building, and cognitive growth, as CEO Jevan Nagarajah notes: “Osteopontin is well known to be beneficial for revitalising and developing the human bosy, we provide access to it as an ingredient for the first time.”
This versatile hero ingredient fits seamlessly into premium nutraceuticals, wellness products, and collagen blends (a $5B market), sports formulas, women’s health, elderly care, and kids’ nutrition – delivering nutraceutical leaders a sustainable edge with robust academic support. Better Dairy is engaging multiple major customers positioning it as a go-to supplier amid surging demand in this enormous global nutraceuticals space, fueled by high margins ($4,000/kg buyers). Happiness Capital’s backing since 2020 propels this path to dominance.

Hackney-based with a world vision, Better Dairy boasts a top-tier team of biotechnologolists and food ingredient experts. While a biotech powerhouse, it eyes nutraceutical supremacy, gearing for funding, scaling, and US launch.

Founded in 2020, Better Dairy secured £1.6m seed from Happiness Capital – a B-Corp investor drawn to its founder’s drive – followed by £16.2m Series A in January 2022. Short-term goals hit proof-of-concept and regulatory wins for osteopontin, unlocking partnerships and production scale.